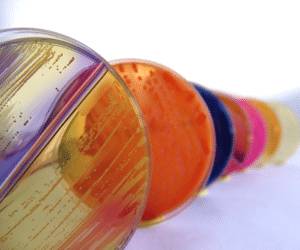
Что такое стрептококк пиогенес

Стрептококк пиогенес (Streptococcus pyogenes) — бактерия, вызывающая серьезные инфекционные заболевания у детей и взрослых. Знание особенностей этого микроорганизма, его симптомов и методов лечения важно для диагностики и предотвращения осложнений. В статье рассмотрим проявления инфекции, эффективные лекарственные препараты и народные средства, что поможет читателям лучше ориентироваться в вопросах здоровья и выборе лечения.
Что такое пиогенный стрептококк
В большинстве случаев патологические процессы затрагивают органы дыхания или пищеварения. При ослабленной иммунной системе бактерии начинают активно развиваться и размножаться. Ранняя диагностика и лечение под наблюдением специалиста помогут избежать серьезных последствий и осложнений. Инфекция проникает в организм человека, чаще всего, воздушно-капельным путем.
Под микроскопом бактерия имеет форму шара. Она получила свое название благодаря способности оказывать негативное воздействие на кровяные клетки, разрушая их. Стрептококковая инфекция может вызвать множество серьезных заболеваний. Токсины, выделяемые бактериями, оказывают разрушительное влияние не только на клетки крови, но и повреждают ткани сердца, а также расширяют мелкие сосуды.
Стрептококк пиогенес, или Streptococcus pyogenes, является одним из наиболее известных патогенных микроорганизмов, вызывающих различные инфекции у человека. Врачи отмечают, что этот бактерий может вызывать заболевания, начиная от легких инфекций, таких как ангина и фарингит, до более серьезных состояний, включая скарлатину и некротизирующий фасциит. Специалисты подчеркивают важность своевременной диагностики и лечения, так как стрептококковая инфекция может привести к осложнениям, включая ревматическую лихорадку и гломерулонефрит. Профилактика, включая соблюдение гигиенических норм и вакцинацию, также играет ключевую роль в снижении заболеваемости. Врачи рекомендуют обращать внимание на симптомы и не игнорировать их, чтобы избежать серьезных последствий для здоровья.
https://youtube.com/watch?v=3wluMc6HAW4
Клиническая картина
Заболевание проявляется ярко как у взрослых, так и у детей. Знание этих симптомов поможет вовремя обратиться за медицинской помощью. Признаки Streptococcus Pyogenes включают:
- Общая слабость и усталость.
- Уменьшение активности, дети становятся менее подвижными и молчаливыми, часто хотят спать.
- Повышение температуры тела, иногда до 40 градусов.
- Воспаление гланд, при осмотре врач заметит значительное увеличение миндалин.
- Увеличение лимфатических узлов на шее.
- Головная боль.
- Миндалины покрываются характерным налетом.
- Боль в горле усиливается при глотании.
- Краснота в области зева.
Узнайте, как лечить кашель с помощью каланхоэ.
Голос пациента становится тихим и приглушенным, открывать рот становится болезненно и неприятно. При появлении первых симптомов важно обратиться в медицинское учреждение. Самолечение может привести к серьезным последствиям. Врачи настоятельно рекомендуют избегать экспериментов, особенно когда речь идет о детях.
| Аспект | Описание | Значение для человека |
|---|---|---|
| Название | Streptococcus pyogenes (Стрептококк пиогенес) | Бактерия, вызывающая широкий спектр заболеваний. |
| Тип микроорганизма | Грамположительная бактерия, сферической формы, образующая цепочки. | Отличается от других бактерий по строению клеточной стенки и форме. |
| Место обитания | Чаще всего обитает на слизистых оболочках верхних дыхательных путей и коже человека. | Человек является основным резервуаром инфекции. |
| Пути передачи | Воздушно-капельный, контактный (через поврежденную кожу), реже пищевой. | Высокая контагиозность, особенно в закрытых коллективах. |
| Основные заболевания | Фарингит (ангина), скарлатина, рожа, импетиго, целлюлит, некротизирующий фасциит. | Широкий спектр клинических проявлений, от легких до жизнеугрожающих. |
| Осложнения | Острая ревматическая лихорадка, гломерулонефрит, сепсис, токсический шок. | Могут привести к необратимым повреждениям органов и систем. |
| Факторы вирулентности | М-белок, стрептолизин О и S, гиалуронидаза, стрептокиназа, экзотоксины. | Позволяют бактерии прикрепляться к тканям, разрушать клетки, распространяться и вызывать интоксикацию. |
| Диагностика | Бактериологический посев, экспресс-тесты на антигены, ПЦР. | Важна для своевременного назначения адекватного лечения. |
| Лечение | Антибиотики пенициллинового ряда (или макролиды при аллергии). | Эффективно при своевременном начале, предотвращает развитие осложнений. |
| Профилактика | Соблюдение гигиены, изоляция больных, своевременное лечение. | Снижает риск распространения инфекции. |
Методы лечения
Лечение стрептококковой инфекции, вызванной пиогенными стрептококками, включает применение антибиотиков. Врачи также рекомендуют пациентам использовать иммуномодулирующие препараты местного действия.
Использование народных средств возможно только после консультации с врачом. Комплексный подход к терапии является необходимым, так как только рецепты народной медицины не способны полностью устранить заболевание. Они могут лишь помочь облегчить симптомы недуга.
https://youtube.com/watch?v=RTYgeuv-87Y
Терапия для взрослых
Лечение стрептококка пиогенного требует профессионального подхода. Взрослым пациентам следует строго следовать указаниям врача. Необходимо чаще полоскать горло, принимать антибиотики и средства для укрепления иммунной системы.
Кроме того, врач может рекомендовать физиотерапевтические процедуры.
Важно соблюдать сбалансированное питание и избегать продуктов и блюд, которые могут негативно сказаться на состоянии слизистой горла, вызывая ее раздражение.
Лечение стрептококка у детей
Лечение заболеваний у детей проводится по аналогии с методами, применяемыми для взрослых, но с учетом возрастных особенностей. Врач корректирует дозировки медикаментов и может рекомендовать специальные средства для обработки горла, такие как спрей Аквалор.
Некоторым детям специалисты могут не назначать иммуномодулирующие препараты. Крайне важно начинать терапию при первых признаках болезни и строго следовать указаниям врача, чтобы предотвратить возможные осложнения.
Медикаментозная терапия
Как и чем лечить пиогенный стрептококк может объяснить только врач. Специалист учитывает общее состояние пациента и прогрессирование заболевания, подбирая наиболее эффективные медикаменты:
- Спрей Биопарокс. Это местный антибактериальный препарат, который применяется при инфекциях верхних дыхательных путей. Обычно курс лечения составляет около недели.
- Ампициллин, Амоксиклав, Хиконцил. Эти пенициллиновые препараты системного действия назначаются пациентам с воспалением миндалин и высокой температурой. Длительность терапии варьируется от 7 до 10 дней.
- Имудон, Эргоферон, Циклоферон. Иммуномодуляторы, действующие как местно, так и системно, помогают поддерживать иммунные силы организма и бороться с инфекцией.
Кроме того, пациентам рекомендуется увеличить потребление жидкости, чтобы способствовать выведению токсинов и продуктов жизнедеятельности патогенных микроорганизмов. Рекомендуются чай, морсы и соки. Витамин С способствует укреплению сосудистых стенок и ускоряет процесс выздоровления.
Нетрадиционные средства
Народные методы лечения могут быть использованы в дополнение к традиционным медицинским препаратам. Перед началом терапии важно проконсультироваться с врачом. Лечение Streptococcus Pyogenes с помощью народных средств можно осуществлять следующим образом:
- Рекомендуется применять антисептические настойки для полоскания горла. В этом случае подойдут эвкалипт, ромашка и календула. Эти средства помогут не только уменьшить воспаление, но и удалить патогенные микроорганизмы из миндалин.
- Больному следует употреблять иммуностимулирующие отвары или настои. Для их приготовления можно использовать плоды шиповника, эхинацею, а также листья или корень элеутерококка.
- Травы, произрастающие в Алтае и на Кавказе, обладают тонизирующим и укрепляющим эффектом.
Народные рецепты способствуют укреплению организма, выведению токсинов и снижению неприятных симптомов, связанных с патологическими процессами.
Как правильно полоскать горло Ротоканом?
Заключение
Специалисты настоятельно советуют заботиться о своем здоровье. Стрептококки могут находиться в организме человека без каких-либо симптомов. Однако после общения с зараженным человеком или при ослаблении иммунной системы они могут активизироваться. Игнорирование лечения заболеваний горла может привести к серьезным последствиям. Воспалительные процессы могут спуститься в нижние дыхательные пути, что способствует возникновению опасных заболеваний.
https://youtube.com/watch?v=a6edcyahZyA
Профилактика инфекций, вызванных стрептококком пиогенес
Профилактика инфекций, вызванных стрептококком пиогенес, является важной задачей как для медицинских работников, так и для населения в целом. Стрептококк пиогенес (Streptococcus pyogenes) — это бактерия, которая может вызывать широкий спектр заболеваний, начиная от легких инфекций, таких как фарингит и скарлатина, и заканчивая более серьезными состояниями, такими как некротизирующий фасциит и стрептококковый шок. Профилактика инфекций, вызванных этой бактерией, включает в себя несколько ключевых аспектов.
1. Личная гигиена: Одним из самых эффективных способов предотвращения инфекций является соблюдение правил личной гигиены. Регулярное мытье рук с мылом, особенно после контакта с больными людьми или после посещения общественных мест, значительно снижает риск передачи инфекции. Также важно избегать касания лица, особенно глаз, носа и рта, грязными руками.
2. Избегание близкого контакта: Стрептококк пиогенес передается воздушно-капельным путем, поэтому важно избегать близкого контакта с людьми, у которых есть симптомы инфекции, такие как кашель, боль в горле или высокая температура. Если кто-то из членов семьи заболел, рекомендуется ограничить физический контакт и использовать отдельные предметы личной гигиены.
3. Вакцинация: На данный момент не существует вакцины, специально разработанной для предотвращения инфекций, вызванных стрептококом пиогенес. Однако вакцинация против других инфекционных заболеваний, таких как грипп, может помочь снизить риск осложнений и ослабить иммунную систему, что делает организм более уязвимым к стрептококковым инфекциям.
4. Своевременное лечение: При появлении первых симптомов инфекции, таких как боль в горле, высокая температура или сыпь, важно обратиться к врачу для диагностики и назначения лечения. Раннее начало антибиотикотерапии может предотвратить развитие серьезных осложнений и снизить риск передачи инфекции другим людям.
5. Образование и информирование: Повышение осведомленности о стрептококке пиогенес и связанных с ним инфекциях среди населения также играет важную роль в профилактике. Образовательные программы, направленные на информирование о симптомах, способах передачи и методах профилактики, могут помочь людям лучше защищать себя и своих близких.
В заключение, профилактика инфекций, вызванных стрептококком пиогенес, требует комплексного подхода, включающего личную гигиену, избегание контактов с больными, своевременное обращение за медицинской помощью и повышение осведомленности о данной проблеме. Соблюдение этих рекомендаций поможет снизить риск заражения и распространения инфекции в обществе.
Диагностика стрептококковой инфекции
Клиническая диагностика начинается с оценки симптомов, которые могут варьироваться в зависимости от типа инфекции. Наиболее распространенные проявления включают боль в горле, лихорадку, увеличение лимфатических узлов, а также кожные высыпания. Важно учитывать анамнез пациента, включая возможные контакты с инфицированными людьми и наличие сопутствующих заболеваний.
Лабораторные исследования играют ключевую роль в подтверждении диагноза. Одним из наиболее распространенных методов является быстрый антигенный тест, который позволяет выявить антигены Streptococcus pyogenes в образцах мазка из горла. Этот тест обладает высокой специфичностью, но может иметь низкую чувствительность, что иногда требует подтверждения с помощью культуры.
Культуральный метод заключается в посеве образца на питательную среду, что позволяет изолировать и идентифицировать бактерии. Этот метод считается золотым стандартом диагностики, так как он позволяет не только подтвердить наличие стрептококка, но и определить его чувствительность к антибиотикам. Однако культура требует больше времени для получения результатов, обычно от 24 до 48 часов.
Кроме того, серологические тесты могут быть использованы для выявления антител к стрептококковым антигенам, что может помочь в диагностике постстрептококковых осложнений, таких как ревматизм или гломерулонефрит. Эти тесты, как правило, менее распространены в остром периоде заболевания, но могут быть полезны в хронических случаях.
Инструментальные методы, такие как ультразвуковое исследование или рентгенография, могут быть применены в случаях, когда инфекция вызывает осложнения, например, абсцессы или пневмонию. Эти методы помогают визуализировать пораженные области и оценить степень распространения инфекции.
Важно отметить, что диагностика стрептококковой инфекции должна проводиться квалифицированным медицинским специалистом, так как неправильная интерпретация результатов может привести к неадекватному лечению и развитию серьезных осложнений. Раннее выявление и правильная диагностика являются ключевыми факторами для успешного лечения и предотвращения осложнений, связанных с инфекцией, вызванной Streptococcus pyogenes.
Сравнение с другими патогенными микроорганизмами
Стрептококк пиогенес (Streptococcus pyogenes) является одним из наиболее известных патогенных микроорганизмов, вызывающих широкий спектр инфекционных заболеваний у человека. Важно рассмотреть его в контексте других патогенных бактерий, чтобы понять его уникальные характеристики и клиническое значение.
В отличие от других стрептококков, таких как Streptococcus pneumoniae, который в основном вызывает пневмонию и менингит, стрептококк пиогенес чаще всего ассоциируется с кожными инфекциями, такими как импетиго, а также с фарингитом и тонзиллитом. Эти заболевания могут быть как легкими, так и тяжелыми, в зависимости от состояния иммунной системы пациента и наличия сопутствующих факторов.
Сравнивая стрептококк пиогенес с стафилококками, такими как Staphylococcus aureus, можно отметить, что оба микроорганизма могут вызывать кожные инфекции, однако стрептококк пиогенес чаще приводит к более серьезным осложнениям, таким как ревматическая лихорадка и гломерулонефрит. Эти осложнения возникают из-за аутоиммунного ответа организма на инфекцию, что не характерно для инфекций, вызванных стафилококками.
Кроме того, стрептококк пиогенес выделяет различные экзотоксины, которые могут вызывать токсический шок и некротизирующий фасциит, что делает его особенно опасным. В то время как некоторые другие патогенные микроорганизмы, такие как Escherichia coli, могут вызывать серьезные инфекции, их механизмы патогенности и клинические проявления отличаются от таковых у стрептококка пиогенес.
Важно также отметить, что стрептококк пиогенес имеет высокую вирулентность благодаря своей способности к образованию капсулы, что затрудняет фагоцитоз иммунными клетками. Это свойство отличает его от других бактерий, таких как Lactobacillus, которые, хотя и являются полезными для организма, не обладают патогенными свойствами.
Таким образом, стрептококк пиогенес выделяется среди других патогенных микроорганизмов благодаря своей способности вызывать разнообразные и потенциально опасные инфекции, а также благодаря уникальным механизмам патогенности. Понимание этих различий имеет важное значение для диагностики и лечения инфекций, вызванных этим микроорганизмом.